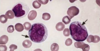

Haematological Cancer Flashcards
(64 cards)
What does the name leukaemia mean?
- leuk = leuocytes
- aemia = blood
What is leukaemia?
- malignant (uncontrolled) proliferation of primitive haematopoetic cells in the bone marrow
What does leukaemia do to the bone marrow?
- causes bone marrow failure
- bone marrow fills with blast cells
- poor maturation of RBCs causes anaemia
Does leukaemia affect just WBCs?
- no
- can affect WBCs, RBCs and platlets
When comparing leakaemia and lymphoma, which is a solid and which is a liquid tumour?
- leukaemia = liquid (blood)
- lymphoma = solid (lymph nodes)
When comparing leukaemia and lymphoma, which cells are generally affected?
- leukaemia = myeloid and lymphoid cells (all bone marrow cells)
- lymphoma = lymphoid cells
When looking at cell lines from the bone marrow we talk about haemopoietic stem cells, which are then able to differentiate into myeloid and lymphoid stem cells. What are myeloid stem cells?
- WBCs
- basophils, esoinophils, neutrophils, megakaryocyte (platelets), monocytes and erythrocytes (RBCs)

When looking at cell lines from the bone marrow we talk about haemopoietic stem cells, which are then able to differentiate into myeloid and lymphoid stem cells. What are lymphoid stem cells?
- Lymphocytes
- B cells, T cells and Natural killer cells

What genetic abnormalities are linked with leukaemia?
- down syndrome
- genetic twins
Drugs that are used to treat a disease can increase the risk of developing leukaemia, what cancer treatments can increase the risk of leukaemia?
- chemotherapy drugs
- radiology
What is the human T lymphotropic virus (HTLV-1)?
- virus similiar to HIV
- can cause leukaemia
In leukaemia there is an acute and chronic form. What are the 2 acute forms of leukaemia?
- acute lymphoblastic (blast = immature cells)
- acute myeloid

In leukaemia there is an acute and chronic form. What are the 2 chronic forms of leukaemia?
- chronic lymphocytic
- chronic myeloid

In acute lymphoblastic and acute myeloid leukaemia, are they dangerous and who do they generally affect?
- very agressive and rapid spreading
- younger patients
- immature cells affected (blasts = immature cells) in bone marrow
In chronic lymphocytic and chronic myeloid leukaemia, are they dangerous and who do they generally affect?
- generally gradual onset
- affect older patients
- mature cells affected in bone marrow
Which of the cells in the image below is a neutrophil?

- a is a neutrophil
- multi lobulated cell
Which of the cells in the image below is a eosinophil?

- b is esinophil
- stains very pink of H&E stain
Which of the cells in the image below is a basophil??

- c is basophil
- appears like a large platelet with no clear nucleus
Which of the cells in the image below is a monocyte?

- d is a monocyte
- nucleus looks like a kidney bean
Which of the cells in the image below is a lymphocyte?

- e is a lymphocyte
- nucleus fills most of the cell
Which of the cells in the image below is a blast cell?

- f is a blast cell
- irregular nuclear and cytoplasm has odd shape
What ages is acute lymphoblastic leukaemia most common in?
- childhood
- most common malignancy in children
What ages is acute myeloid leukaemia most common in?
- median age is 65
- can occur at any age
In bone marrow failure, common in leukaemia, what are 2 common signs that patients may present with, similar to asthma?
- fatigue
- breathlessness